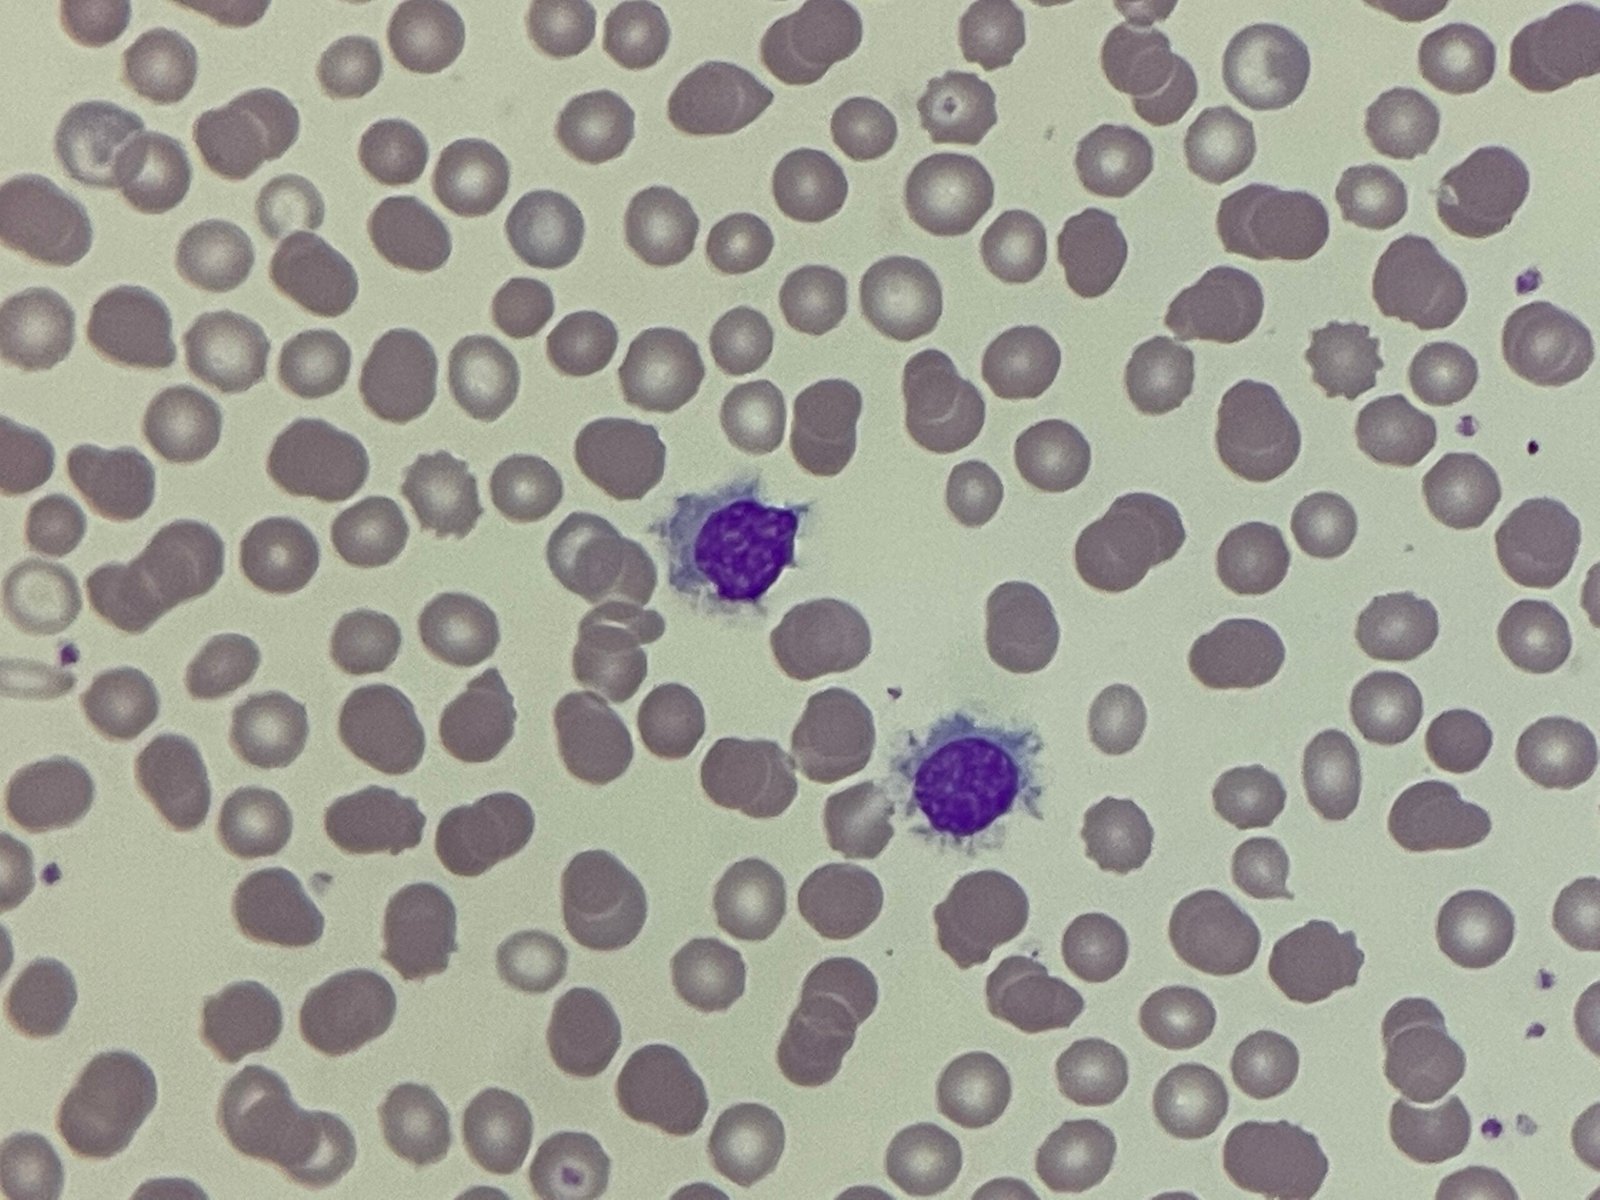
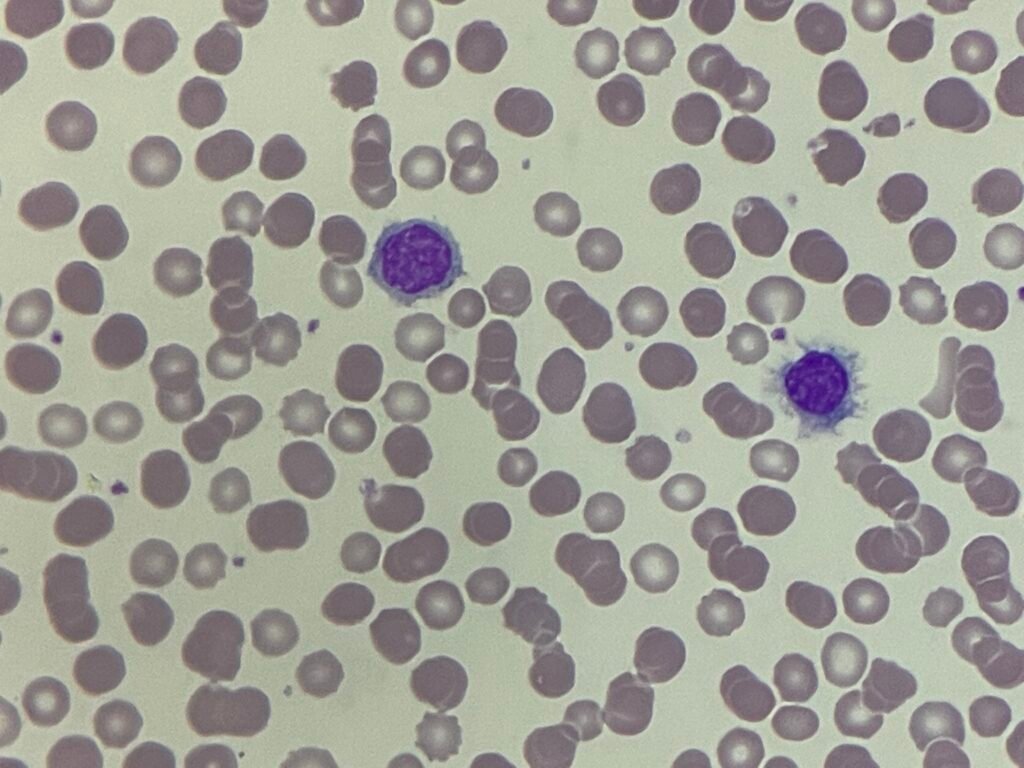
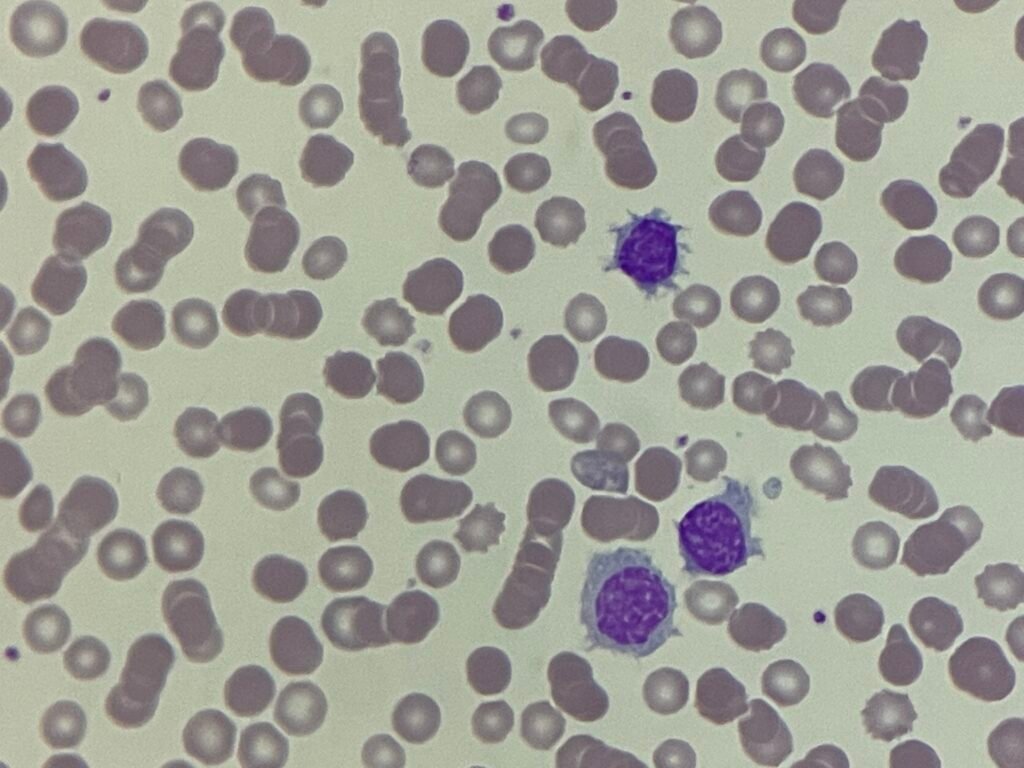
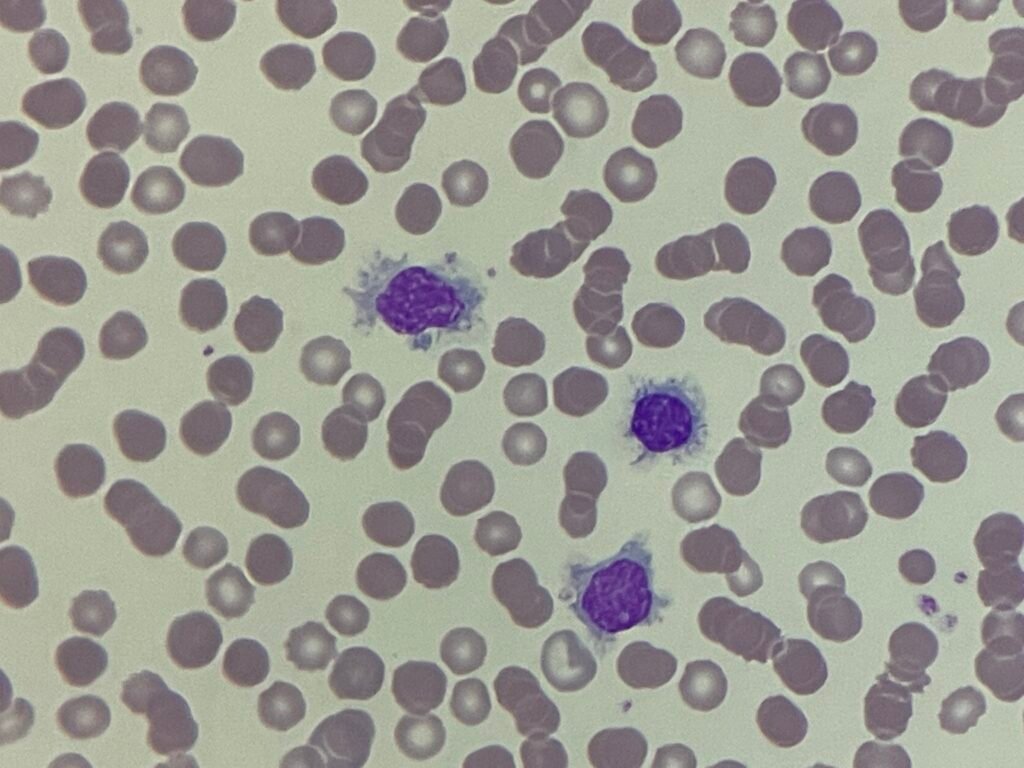
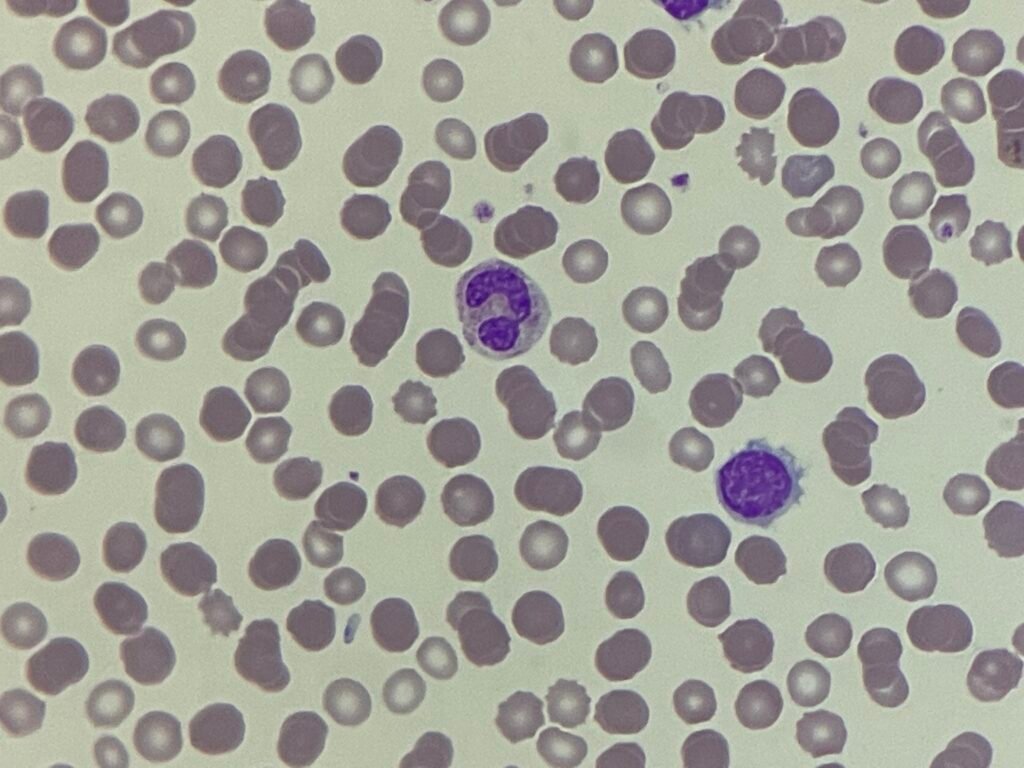
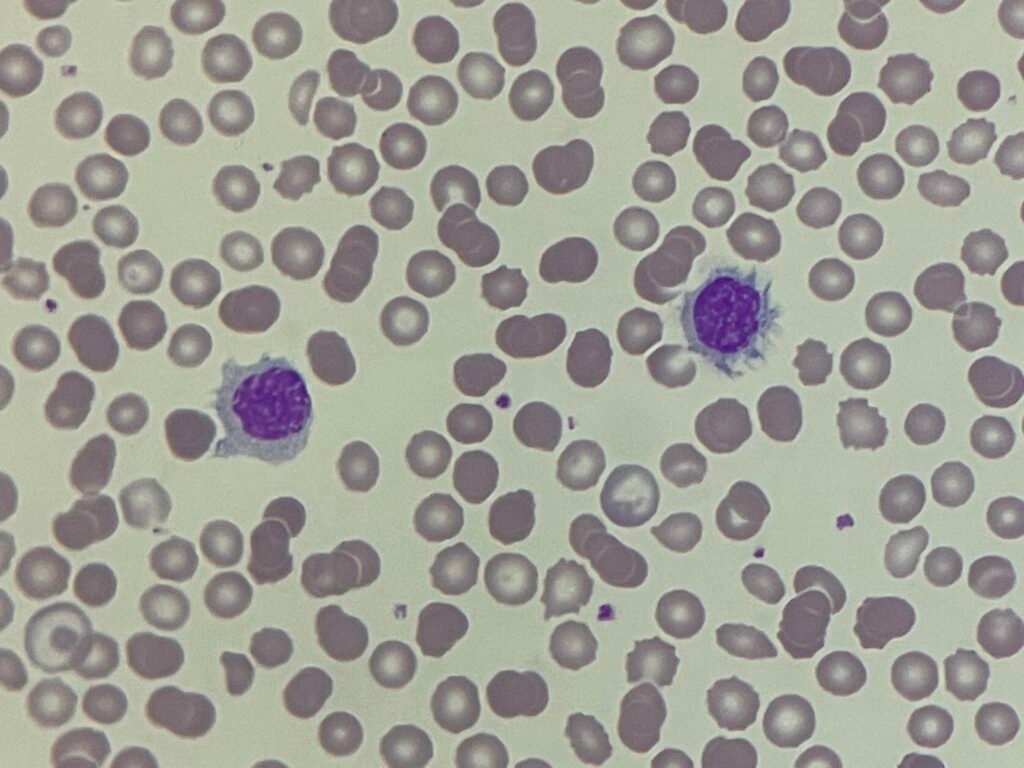

This week’s Morphology Monday features a patient who presented with fatigue and splenomegaly on examination. Routine bloods showed a significant lymphocytosis, prompting further investigation.
Full blood count results:
- WBC: 48.35 ×10⁹/L ↑
- Hb: 94 g/L ↓
- RBC: 3.34 ×10¹²/L ↓
- MCV: 71.4 fL ↓
- MCH: 21.7 pg ↓
- Platelets: 185 ×10⁹/L
- Lymphocytes: 75% (36.26 ×10⁹/L absolute)
Flow cytometry (peripheral blood):
- Positive: CD19, CD20, CD79b, CD11c, CD22, surface IgM
- Negative: CD5, CD10, CD23, CD25, CD103, CD123, Annexin A1
The absence of CD103, CD123, and Annexin A1, alongside surface IgM positivity and strong CD20 expression, helps narrow the differential.
Blood film images are available below. What stands out to you?

What diagnoses would you consider in a patient with persistent lymphocytosis and these flow findings?
5 Comments
Favour SMZL
what makes you say that, why not HCL?
My differential diagnosis:
-Hairy cell leukemia variant
-Splenic marginal zone lymphoma
How would you distinguish between HCL and SMZL? The clue is in the post itself!
Morphology is HCL . But FC favors variant HCL